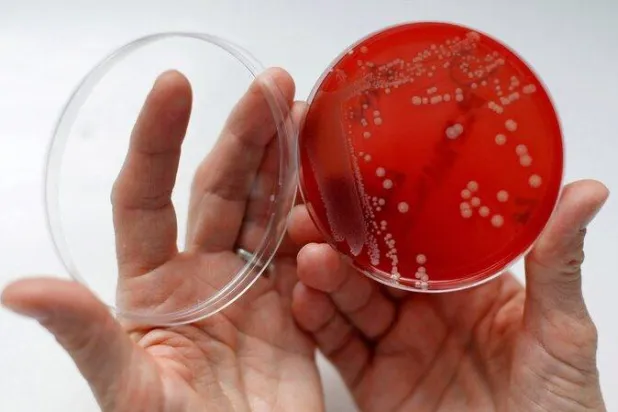
ارتفاع الحرارة يعزّز قدرة البكتيريا على البقاء حيّة (رويترز)

المضادات الحيوية
المضادات الحيوية
معدل وصف المضادات الحيوية لديهم أعلى بـ5 مرات من الأطفال الأصحاء
كشفت دراسة جديدة عن أنّ دواءً يُستخدم لخفض ضغط الدم قد يُشكّل أساساً لعلاج جديد واعد لبكتيريا المكورات العنقودية الذهبية المقاومة للميثيسيلين.
وافقت هيئة الغذاء والدواء الأميركية على علاجين جديدين لمرض السيلان المقاوم للأدوية، يمكن أن يشكلا «نقطة تحوُّل هائلة» في جهود مكافحة العدوى البكتيرية.
نجح فريق بحثي دولي في تطوير علاج جديد يعتمد على الخل مدعوماً بجزيئات نانوية مبتكرة.
كشف باحثون من جامعة ولاية ساو باولو في البرازيل عن مسحوق طبيعي يعتمد على مادة «المورين» المستخلصة من أوراق الجوافة، يتميز بخصائص مضادة للميكروبات.
قد تُسهم مسكنات الألم المتاحة دون وصفة طبية، بما في ذلك الأسيتامينوفين والإيبوبروفين، بشكل غير مباشر في ظهور مقاومة مضادات الميكروبات.
غالباً ما يُعزى تساقط الشعر إلى عوامل مثل الجينات والهرمونات والأمراض والأدوية والشيخوخة. ومع ذلك، قد يُسهم ارتداء قبعة ضيقة في الصلع المؤقت أو الدائم.
توصَّل باحثون في الولايات المتحدة إلى علاج موضعي جديد لالتهابات الأذن الوسطى، عبارة عن چيل يحتوي على مضاد حيوي.
أظهرت دراسة أجراها خبيران في مجال صحة الطفل أن أكثر من 3 ملايين طفل حول العالم لقوا حتفهم في عام 2022 نتيجة للعدوى المقاومة للمضادات الحيوية.
تشير دراسة جديدة إلى أن الأطفال حديثي الولادة الذين تلقوا المضادات الحيوية لعلاج مرض ما، لديهم استجابات مناعية منخفضة للقاحات في مراحل لاحقة من الطفولة.
وجدت دراسة جديدة أن الجسيمات البلاستيكية الدقيقة قد تُسهم في انتشار بكتيريا خارقة خطيرة مقاومة للمضادات الحيوية.
كشفت دراسة عن زيادة مقلقة في استخدام المضادات الحيوية للأطفال دون سنّ الخامسة عند الإصابة بالحمى أو السعال في البلدان النامية، خصوصاً في الكونغو ومصر.
أفادت دراسة نموذجية، نُشرت اليوم (الثلاثاء)، بأنّ 39 مليون شخص في مختلف أنحاء العالم قد يموتون بسبب أمراض مقاومة للمضادات الحيوية خلال السنوات الـ25 المقبلة.
حذّر مسؤولو الصحة في بريطانيا من أن مرض السيلان أصبح مقاوماً بشكل متزايد للمضادات الحيوية، وقد يكون غير قابل للعلاج في المستقبل.
حذّرت دراسة أُجريت في جنوب أفريقيا من أنّ تغيُّر المناخ يسهّل حركة البكتيريا المقاوِمة للمضادّات الحيوية وانتشارها.
كشفت دراسة جديدة أن مقاومة مضادات الميكروبات مرتبطة بوقوع أكثر من مليون حالة وفاة في أفريقيا خلال عام
ذكر تقرير جديد أن المستشفيات والمرافق الصحية في أوكرانيا تواجه «زيادة مثيرة للقلق» في حالات العدوى البكتيرية المقاومة للمضادات الحيوية وسط الحرب مع روسيا.
وصفت منظمة الصحة العالمية في وقت سابق من هذا العام مقاومة مضادات الميكروبات، أي قدرة مسببات الأمراض على تجنب التدخلات الطبية، بأنها واحدة من أكبر 10 تهديدات للصحة العالمية. وفي الولايات المتحدة وحدها، وفقاً لتقرير حديث صادر عن مراكز السيطرة على الأمراض والوقاية منها، يموت 35 ألف شخص سنوياً بسبب العدوى المقاومة للمضادات الحيوية، بحسب تقرير لمجلة «تايم». وتشير دراسة جديدة نُشرت في المجلة الطبية البريطانية (بي إم جي) إلى سبب رئيسي للمشكلة: الأطباء يصفون المضادات الحيوية عندما لا ينبغي لهم ذلك.
لم تشترك بعد
انشئ حساباً خاصاً بك لتحصل على أخبار مخصصة لك ولتتمتع بخاصية حفظ المقالات وتتلقى نشراتنا البريدية المتنوعة